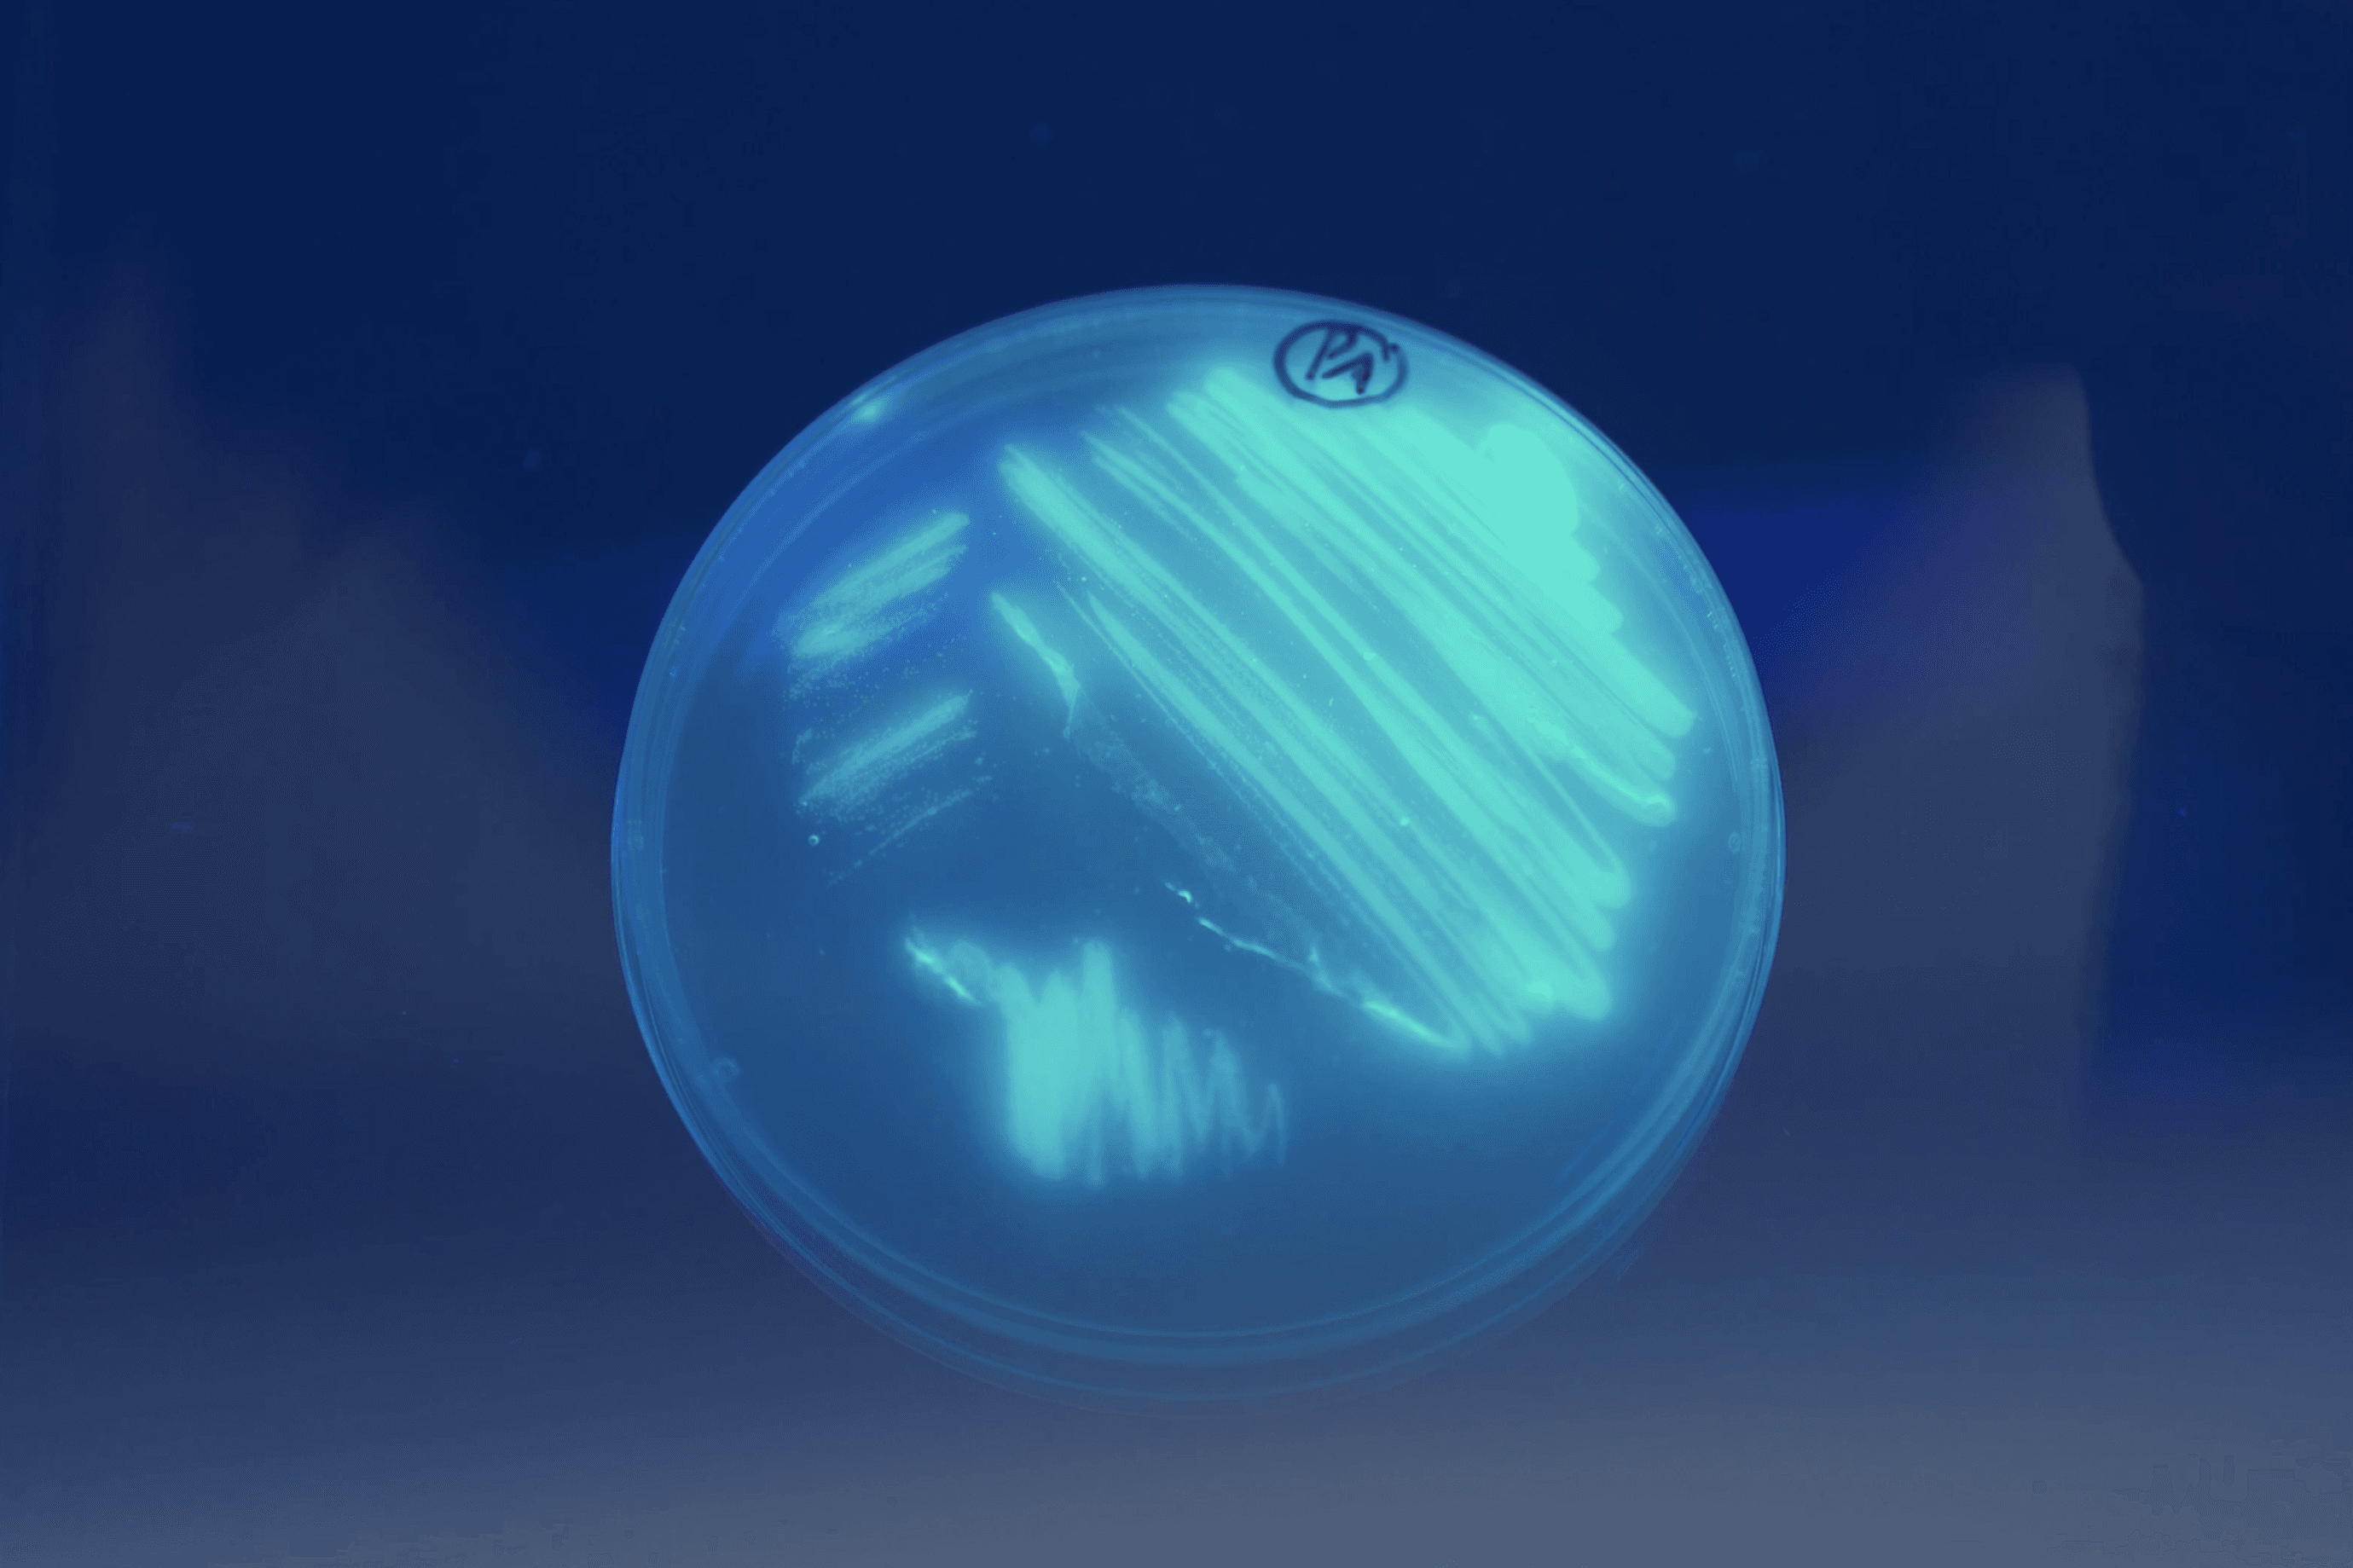

Our team of licensed professionals is dedicated to supporting companies every stage of care
Our Mission
For Pharmilab, care, leadership, and closeness to the customer mean much more than commercial success. These values reflect a deep sense of responsibility towards clients, employees, and society – a responsibility that Pharmilab will continuously strive to uphold.
Team Members

Luís Figueiredo

Daniel Ribeiro

Cátia Costa
Head of Laboratory

Margarida Lindo
Business Development

Sílvio Ramalheira
Customer Manager

José Pereira
Customer manager

Beatriz Simão
Regulatory Affairs Consultant

Madalena Gil
Regulatory Affairs Consultant

Ana Dinis
Regulatory Affairs Consultant

Rita Dias
Regulatory Affairs Consultant

Guilherme Arrais
Regulatory Affairs Consultant

Mariana Ferreira
Regulatory Affairs Officer

Mariana Gil
Regulatory Affairs Officer

Mariana Duarte
Regulatory Affairs Officer

Isaura Pestana
Regulatory Affairs Officer

Sandro Lopes
Specialist Lab Technician

Daniela Geitoeira
Specialist Lab Technician

Rita Mendes
Specialist Lab Technician

Joana Oliveira
Lab Technician

Beatriz Mendes
Lab Technician

Pedro Paiva
Lab Technician

Catarina Batista
Lab Technician

Ivo Roxo
Lab Technician

Hugo Ribeiro
Admin Officer

Miguel Ramos
Finance and Admin Officer

Anastasiya Grachova
Designer
